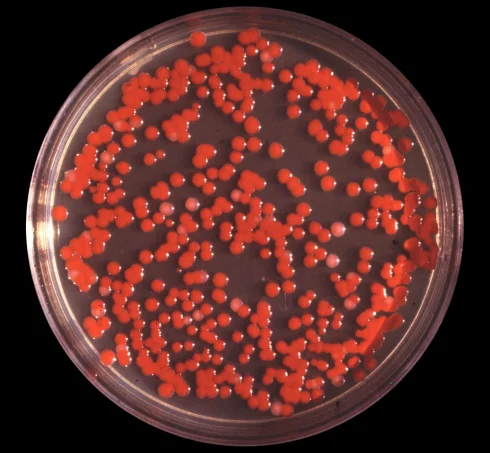
سراشیا مارسسنس: زیستگاه، مورفولوژی، ویژگی ها و بیماری ها

آرشیو دسته بندی: بیماری ها
سرطان چشم (Eye Cancer) چیست؟ علائم، تشخیص، درمان و پیشگیری
مقدمهای بر سرطان چشم سرطان چشم میتواند به هر سرطانی که از چشم شروع میشود[بیشتر بخوانید]
سودوموناس پوتیدا: زیستگاه، مورفولوژی، ویژگیها و بیماریزایی
سودوموناس پوتیدا چیست؟ سودوموناس پوتیدا (Pseudomonas putida) یک باکتری میلهای شکل تاژکدار گرم منفی است[بیشتر بخوانید]
4 دیدگاه
رتینوبلاستوما چیست؟ علائم، تشخیص، مراحل و درمان
رتینوبلاستوما چیست؟ رتینوبلاستوما (Retinoblastoma) سرطانی است که در شبکیه (retina)، قسمت پشتی چشم شروع میشود.[بیشتر بخوانید]
6 دیدگاه
سرطان پوست سلول بازال و سنگفرشی چیست؟ علائم، تشخیص و درمان
مقدمهای بر سرطان پوست سلول بازال و سنگفرشی سرطان پوست سلول بازال و سنگفرشی شایع[بیشتر بخوانید]
2 دیدگاه
کاندیدا آلبیکنس: زیستگاه، مورفولوژی، بیماری و محیط های کشت
زیستگاه کاندیدا آلبیکنس زیستگاه طبیعی: غشاهای مخاطی انسان و سایر حیوانات خون گرم. همچنین در[بیشتر بخوانید]
4 دیدگاه
آسپرژیلوس نایجر چیست؟ مورفولوژی، زیستگاه و محیط کشت
آسپرژیلوس نایجر چیست؟ آسپرژیلوس نایجر شایعترین گونه آسپرژیلوس است. نام آن برگرفته از نام لاتین[بیشتر بخوانید]
3 دیدگاه
مولتیپل میلوما (Multiple Myeloma) چیست؟ انواع، علائم، تشخیص و درمان
مقدمهای بر مولتیپل میلوما سرطان زمانی شروع میشود که سلولها شروع به رشد خارج از[بیشتر بخوانید]
14 دیدگاه
سراشیا مارسسنس: زیستگاه، مورفولوژی، ویژگی ها و بیماری ها
مقدمهای بر سراشیا مارسسنس سراشیا مارسسنس یک گاماپروتئوباکتری گرم منفی، متحرک، غیر آندوسپور ساز، میلهای[بیشتر بخوانید]
2 دیدگاه
آنوریسم آئورت: بررسی اجمالی علائم، علل، درمان و پیشگیری
آنوریسم آئورت چیست؟ آنوریسم برآمدگی آئورت است. آئورت شریان اصلی است که از قلب حرکت[بیشتر بخوانید]
2 دیدگاه
نوروبلاستوما (Neuroblastoma) چیست؟ علائم، تشخیص، پیشگیری و درمان
مقدمهای بر نوروبلاستوما سرطان زمانی شروع میشود که سلولهای بدن شروع به رشد غیر قابل[بیشتر بخوانید]
18 دیدگاه
ویروس نیپا (NiV):ساختار، انتقال، تکثیر و تظاهرات بالینی
مقدمهای بر ویروس نیپا ویروس نیپا (NiV) یک پاتوژن زئونوز منتقله از خفاش است که[بیشتر بخوانید]
استئوسارکوم (Osteosarcoma) چیست؟ علائم، تشخیص، پیشگیری و درمان
مقدمهای بر استئوسارکوم سرطان زمانی شروع میشود که سلولهای بدن شروع به رشد خارج از[بیشتر بخوانید]
6 دیدگاه
مروری بر ویروس های انکوژنیک
مقدمهای بر ویروس های انکوژنیک ویروسها پاتوژنهای درون سلولی هستند که فقط در سلول زنده[بیشتر بخوانید]
2 دیدگاه
سارکوم بافت نرم چیست؟ انواع، علائم، تشخیص و درمان
مقدمهای بر سارکوم بافت نرم (Soft Tissue Sarcoma) سرطان زمانی شروع میشود که سلولها شروع[بیشتر بخوانید]
34 دیدگاه
لوپوس چیست؟ انواع، علائم، تشخیص، درمان و پیشگیری
لوپوس چیست؟ لوپوس یک بیماری خودایمنی مزمن است که میتواند باعث التهاب در سراسر بدن[بیشتر بخوانید]
فیبرومیالژیا چیست؟ علائم، تشخیص، درمان و پیشگیری
مقدمهای بر فیبرومیالژیا فیبرومیالژیا یک بیماری طولانی مدت است که باعث ایجاد درد گسترده، مشکلات[بیشتر بخوانید]
2 دیدگاه
سرطان تیروئید (Thyroid Cancer) چیست؟ علائم، تشخیص و درمان
مقدمهای بر سرطان تیروئید سرطان تیروئید نوعی سرطان است که از غده تیروئید شروع میشود.[بیشتر بخوانید]
6 دیدگاه
تومورهای استرومال دستگاه گوارش (Gastrointestinal Stromal Tumors) چیست؟ علائم، تشخیص و درمان
مقدمهای بر تومورهای استرومال دستگاه گوارش سرطان زمانی شروع میشود که سلولهای بدن شروع به[بیشتر بخوانید]
10 دیدگاه
آنژیوادم (Angioedema) چیست؟ علائم، علل، تشخیص و درمان
آلرژی تنها یکی از علتهای احتمالی زیاد آن است. آنژیوادم تورم لایه پایینی بافت درست[بیشتر بخوانید]
51 دیدگاه
عفونت ریکتزیا: ریکتسیوزهای ناشی از کنه و تب خالدار
مقدمهای بر عفونت ریکتزیا ریکتزیا یک باکتری کوچک درونسلولی است که اندازهای در حدود 0.3[بیشتر بخوانید]
2 دیدگاه
اسینتوباکتر بومانی (Acinetobacter baumannii): زیستگاه، مورفولوژی، ژنوم، بیماریزایی و درمان
زیستگاه اسینتوباکتر بومانی اولین اسینتوباکتر در خاک در سال 1911 توسط W. Beijerinck کشف شد.[بیشتر بخوانید]
3 دیدگاه